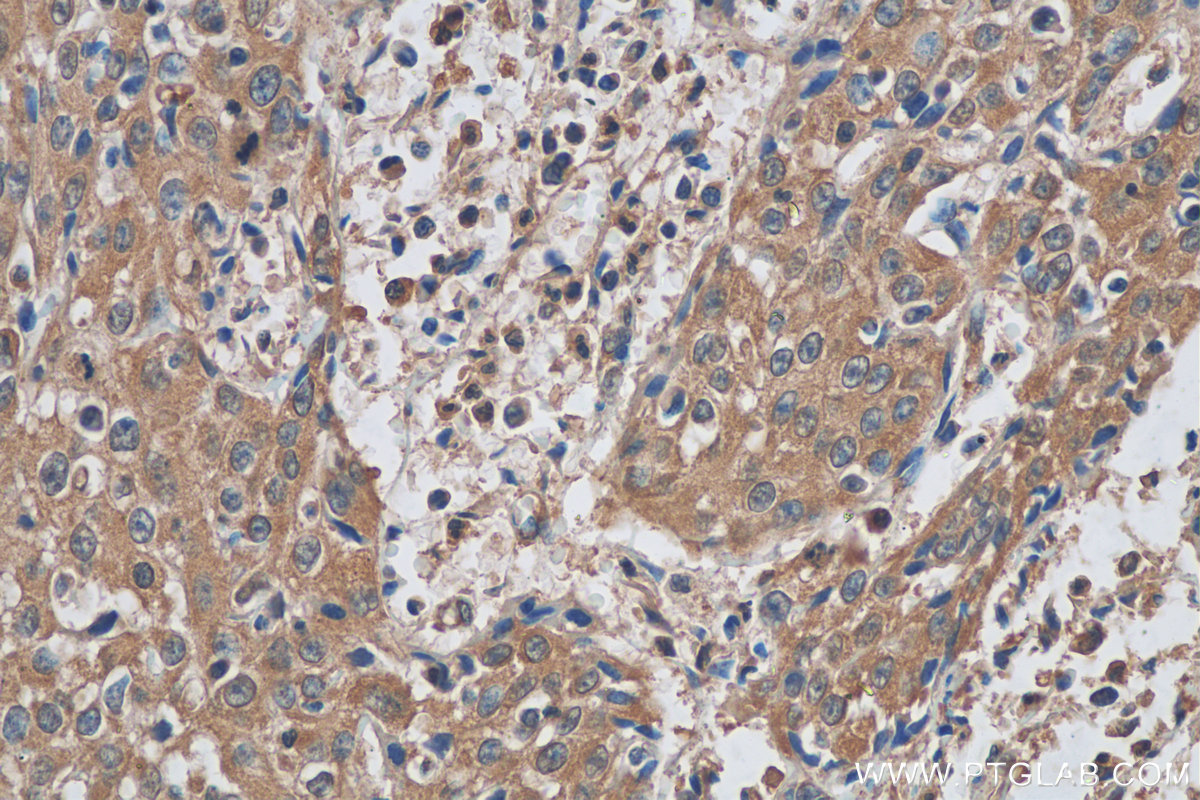

验证数据展示
经过测试的应用
| Positive WB detected in | K-562 cells |
| Positive IHC detected in | human lymphoma tissue, human cervical cancer tissue Note: suggested antigen retrieval with TE buffer pH 9.0; (*) Alternatively, antigen retrieval may be performed with citrate buffer pH 6.0 |
| Positive IF/ICC detected in | HeLa cells |
| Positive FC (Intra) detected in | HepG2 cells |
Mouse monoclonal antibodies of IgM isotype can be detected with "anti-mouse IgG (H+L)" secondary antibodies.
推荐稀释比
| 应用 | 推荐稀释比 |
|---|---|
| Western Blot (WB) | WB : 1:500-1:2000 |
| Immunohistochemistry (IHC) | IHC : 1:20-1:200 |
| Immunofluorescence (IF)/ICC | IF/ICC : 1:400-1:1600 |
| Flow Cytometry (FC) (INTRA) | FC (INTRA) : 0.25 ug per 10^6 cells in a 100 µl suspension |
| It is recommended that this reagent should be titrated in each testing system to obtain optimal results. | |
| Sample-dependent, Check data in validation data gallery. | |
发表文章中的应用
| WB | See 31 publications below |
| IHC | See 1 publications below |
产品信息
60312-1-Ig targets CDK2 in WB, IHC, IF/ICC, FC (Intra), ELISA applications and shows reactivity with human samples.
| 经测试应用 | WB, IHC, IF/ICC, FC (Intra), ELISA Application Description |
| 文献引用应用 | WB, IHC |
| 经测试反应性 | human |
| 文献引用反应性 | human, mouse, bovine |
| 免疫原 |
CatNo: Ag21310 Product name: Recombinant human CDK2 protein Source: e coli.-derived, PET28a Tag: 6*His Domain: 8-210 aa of BC003065 Sequence: EKIGEGTYGVVYKARNKLTGEVVALKKIRLDTETEGVPSTAIREISLLKELNHPNIVKLLDVIHTENKLYLVFEFLHQDLKKFMDASALTGIPLPLIKSYLFQLLQGLAFCHSHRVLHRDLKPQNLLINTEGAIKLADFGLARAFGVPVRTYTHEVVTLWYRAPEILLGCKYYSTAVDIWSLGCIFAEMVTRRALFPGDSEID 种属同源性预测 |
| 宿主/亚型 | Mouse / IgM |
| 抗体类别 | Monoclonal |
| 产品类型 | Antibody |
| 全称 | cyclin-dependent kinase 2 |
| 别名 | 4E2E10, CDKN2, Cell division protein kinase 2, Cyclin dependent kinase 2, Cyclin-dependent kinase 2 |
| 计算分子量 | 33 kDa |
| 观测分子量 | 30 kDa |
| GenBank蛋白编号 | BC003065 |
| 基因名称 | CDK2 |
| Gene ID (NCBI) | 1017 |
| RRID | AB_2881424 |
| 偶联类型 | Unconjugated |
| 形式 | Liquid |
| 纯化方式 | Caprylic acid/ammonium sulfate precipitation |
| UNIPROT ID | P24941 |
| 储存缓冲液 | PBS with 0.02% sodium azide and 50% glycerol, pH 7.3. |
| 储存条件 | Store at -20°C. Stable for one year after shipment. Aliquoting is unnecessary for -20oC storage. |
背景介绍
CDK2(Cyclin-dependent kinase 2) is also named as CDKN2 and belongs to the protein kinase superfamily,CMGC Ser/Thr protein kinase family, CDC2/CDKX subfamily.It is involved in the control of the cell cycle; essential for meiosis, but dispensable for mitosis.It has 2 isoforms produced by alternative splicing.
发表文章
| Species | Application | Title |
|---|---|---|
Oncotarget High expression of N-myc (and STAT) interactor predicts poor prognosis and promotes tumor growth in human glioblastoma. | ||
Oxid Med Cell Longev MICAL2 Contributes to Gastric Cancer Cell Proliferation by Promoting YAP Dephosphorylation and Nuclear Translocation | ||
Genes Nutr Arjunolic acid inhibits Wnt3a-mediated macrophage M2 polarization to suppress osteosarcoma progression | ||
Ecotoxicol Environ Saf The role of ER stress and ATP/AMPK in oxidative stress meditated hepatotoxicity induced by citrinin. | ||
J Hepatocell Carcinoma CYP2C8 Suppress Proliferation, Migration, Invasion and Sorafenib Resistance of Hepatocellular Carcinoma via PI3K/Akt/p27 kip1 Axis | ||
Oncol Res SORBS1 Knockdown Resists S/G2 Arrest and Apoptosis Caused by Polyphyllin H-Induced DNA Damage in Pancreatic Cancer |